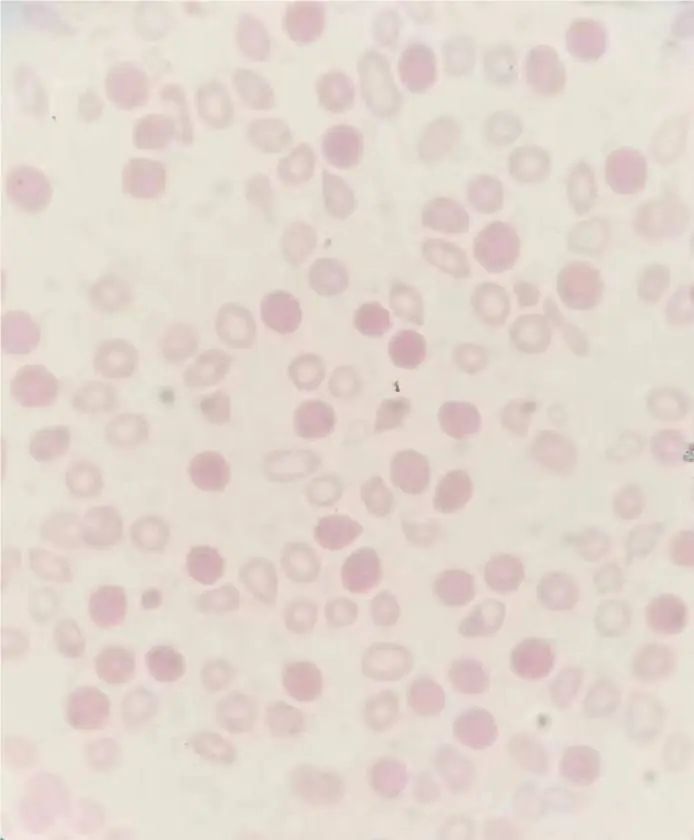

单位 | 文山州人民医院医学检验科
01 前 言
作为一线检验人员,在日常工作中遇到血小板假性减少或者是假性增高,结果超出参考范围,都是常见且都能得到有效纠正的,在繁重的血细胞检测工作中,我们更多关注的是结果是否正常,如果异常,是否达到复检要求?而检测结果正常是很容易被忽视的。该案例为血小板检测结果正常,审核中通过血小板和红细胞直方图发现问题,并及时得到有效纠正,最终为临床提供精准的检验结果。
02 案例经过
患者,女,16岁
主诉:1年前患者无明显诱因出现全身瘀点、瘀斑,无头昏、乏力、咳嗽、咳痰,完善血常规后提示血小板显著减少,完善骨穿后诊断明确为“血小板减少性紫癜”。予激素冲击治疗,患者血小板明显升高、症状好转出院。近1周来患者无明显诱因再次出现牙龈出血、全身瘀点、瘀斑,为进一步治疗门诊以“血小板减少性紫癜”办理住院。
体格检查:全身可见散在瘀点,瘀斑,口腔粘膜散在血泡,牙龈渗血。
临床诊断:特发性血小板减少性紫癜。
★初次血细胞分析结果(图1):
①仪器显示血小板结果为:163×109/L,结果正常,与患者病情不符;
②患者HGB:80G/L、HCT:29.5%、MCV:58.4fl、MCH:16.0pg、MCHC:273g/L;RDW-CV:38.0%符合小细胞低色素性贫血征象;
③红细胞直方图:波峰左移,峰低变宽符合小细胞低色素贫血特征;血小板直方图:10-20fl之间尾部上翘,疑似存在小红细胞?红细胞碎片?大血小板?血小板聚集?的影响。

图1
为验证结果的准确性,次日进行了血细胞分析+网织红细胞、铁蛋白检测及外周血细胞形态检查结果如下:
★复查血细胞分析+网织红细胞结果(图2):
①仪器显示血小板结果为:1×109/L,结果异常,与患者病情相符;
②患者HGB:61G/L、HCT:23.9%、MCV:54.6fl、MCH:13.9pg、MCHC:254g/L;RDW-CV:31.0%符合小细胞低色素性贫血征象;
③红细胞直方图及血小板直方图与图1相同;
④PDW、PCT、MPV结果疑似受干扰,导致结果未出。

图2
★铁蛋白检测结果(图3):铁蛋白明显减低

图3
★外周血细胞形态检查(图4):成熟红细胞形态大小不一,中央浅染区扩大,易见小红细胞;血小板分布极度减少。
图4
03 案例分析
特发性血小板减少性紫癜在临床中比较常见[1]。导致其产生的主要原因为患者自身机体免疫功能出现异常紊乱的情况,进而诱发机体产生自身血小板相关抗体,使血小板的生成出现障碍,或遭到过度破坏[2-3]。如此一来,患者机体外周血中的血小板数量会大幅降低,进而诱发出血症状[4]。
缺铁性贫是最为常见的贫血,指机体中产生血红素的铁原料不足引起红细胞再生功能障碍,进而导致的贫血,血细胞分析表现为小细胞低色素性贫血[5]。
本案例为特发性血小板减少性紫癜伴缺铁性贫血患者,第一次血细胞分析结果血小板正常与患者病情不符,第二次复查为血细胞分析+网织红细胞,血小板结果已达危急值且与病情相符。
日常工作中由于标本量大及医保等诸多问题,患者首次进行血细胞分析时不会加网织红细胞计数,只有怀疑溶血性贫血等才会带网织红细胞计数。
单独血细胞分析对血小板的计数采用的是PLT-I模式,该模式采用的是浮动界标技术,不能排除小红细胞及红细胞碎片等对血小板计数的干扰,故该病例第一次血细胞分析的过程中仪器在计数血小板时误将小红细胞识别为血小板,导致血小板计数误差。
而血细胞分析+网织红细胞对血小板的计数采用的是PLT-O模式,该模式采用的是光学法,可在很大程度上纠正小红细胞、红细胞碎片及血小板聚集等对血小板计数的干扰,该病例第二天复查血细胞分析并带网织红细胞计数,得到血小板的实际结果。
在进行血细胞分析的过程中如遇直方图异常、散在图异常及某些参数无法计数的情况,切记一定要进行血涂片镜检复核,该病例进行外周血细胞形态检查后易见小红细胞且血小板分布极度减少。
04 总 结
在日常工作中,作为一名检验人我们不能单纯依靠仪器的数值就将患者的报告发出去,还需结合患者的病情、检测过程中仪器给出的图形及报警等进行综合分析,特别是血细胞分析如发现直方图异常、散点图异常、某些参数无法计数及某些计数明显增高或减低等情况一定要进行血涂片镜检复核,只有这样我们发出的检验报告才能准确地反应患者的真实病情。
05 专家点评
陆兴热主任技师:
该案例在常规工作中很难被发现且容易让报告审核者忽略,从而导致临床误判误诊,出现不必要的医疗纠纷,案例最终通过镜检结合荧光染色的方法得到有效纠正,值得同行的学习借鉴。
参考文献:
[1]李哲.血栓性血小板减少性紫癜临床特点分析[J].医药前沿,2020,10(19):145-147.
[2]郑慈娜.不同剂量丙种球蛋白联合激素并配合针对性综合护理治疗特发性血小板减少性紫癜的效果观察[J].医药前沿,2020,10(19):162-163.
[3]高恒妙.儿童血栓性血小板减少性紫癜的特点和治疗 现状[J].中国小儿急救医学,2019,26(3):179-183
[4]吴天歌,韩立帅,杨晓佩,等.系统性红斑狼疮合并血栓性血小板减少性紫癜危险因素及临床分析[J].中华风 湿病学杂志,2019,23(7):472-475.
[5]王佳宁.血常规检测鉴别缺铁性贫血与地中海贫血的价值分析[J].当代医学,2021,27(3):154-155.